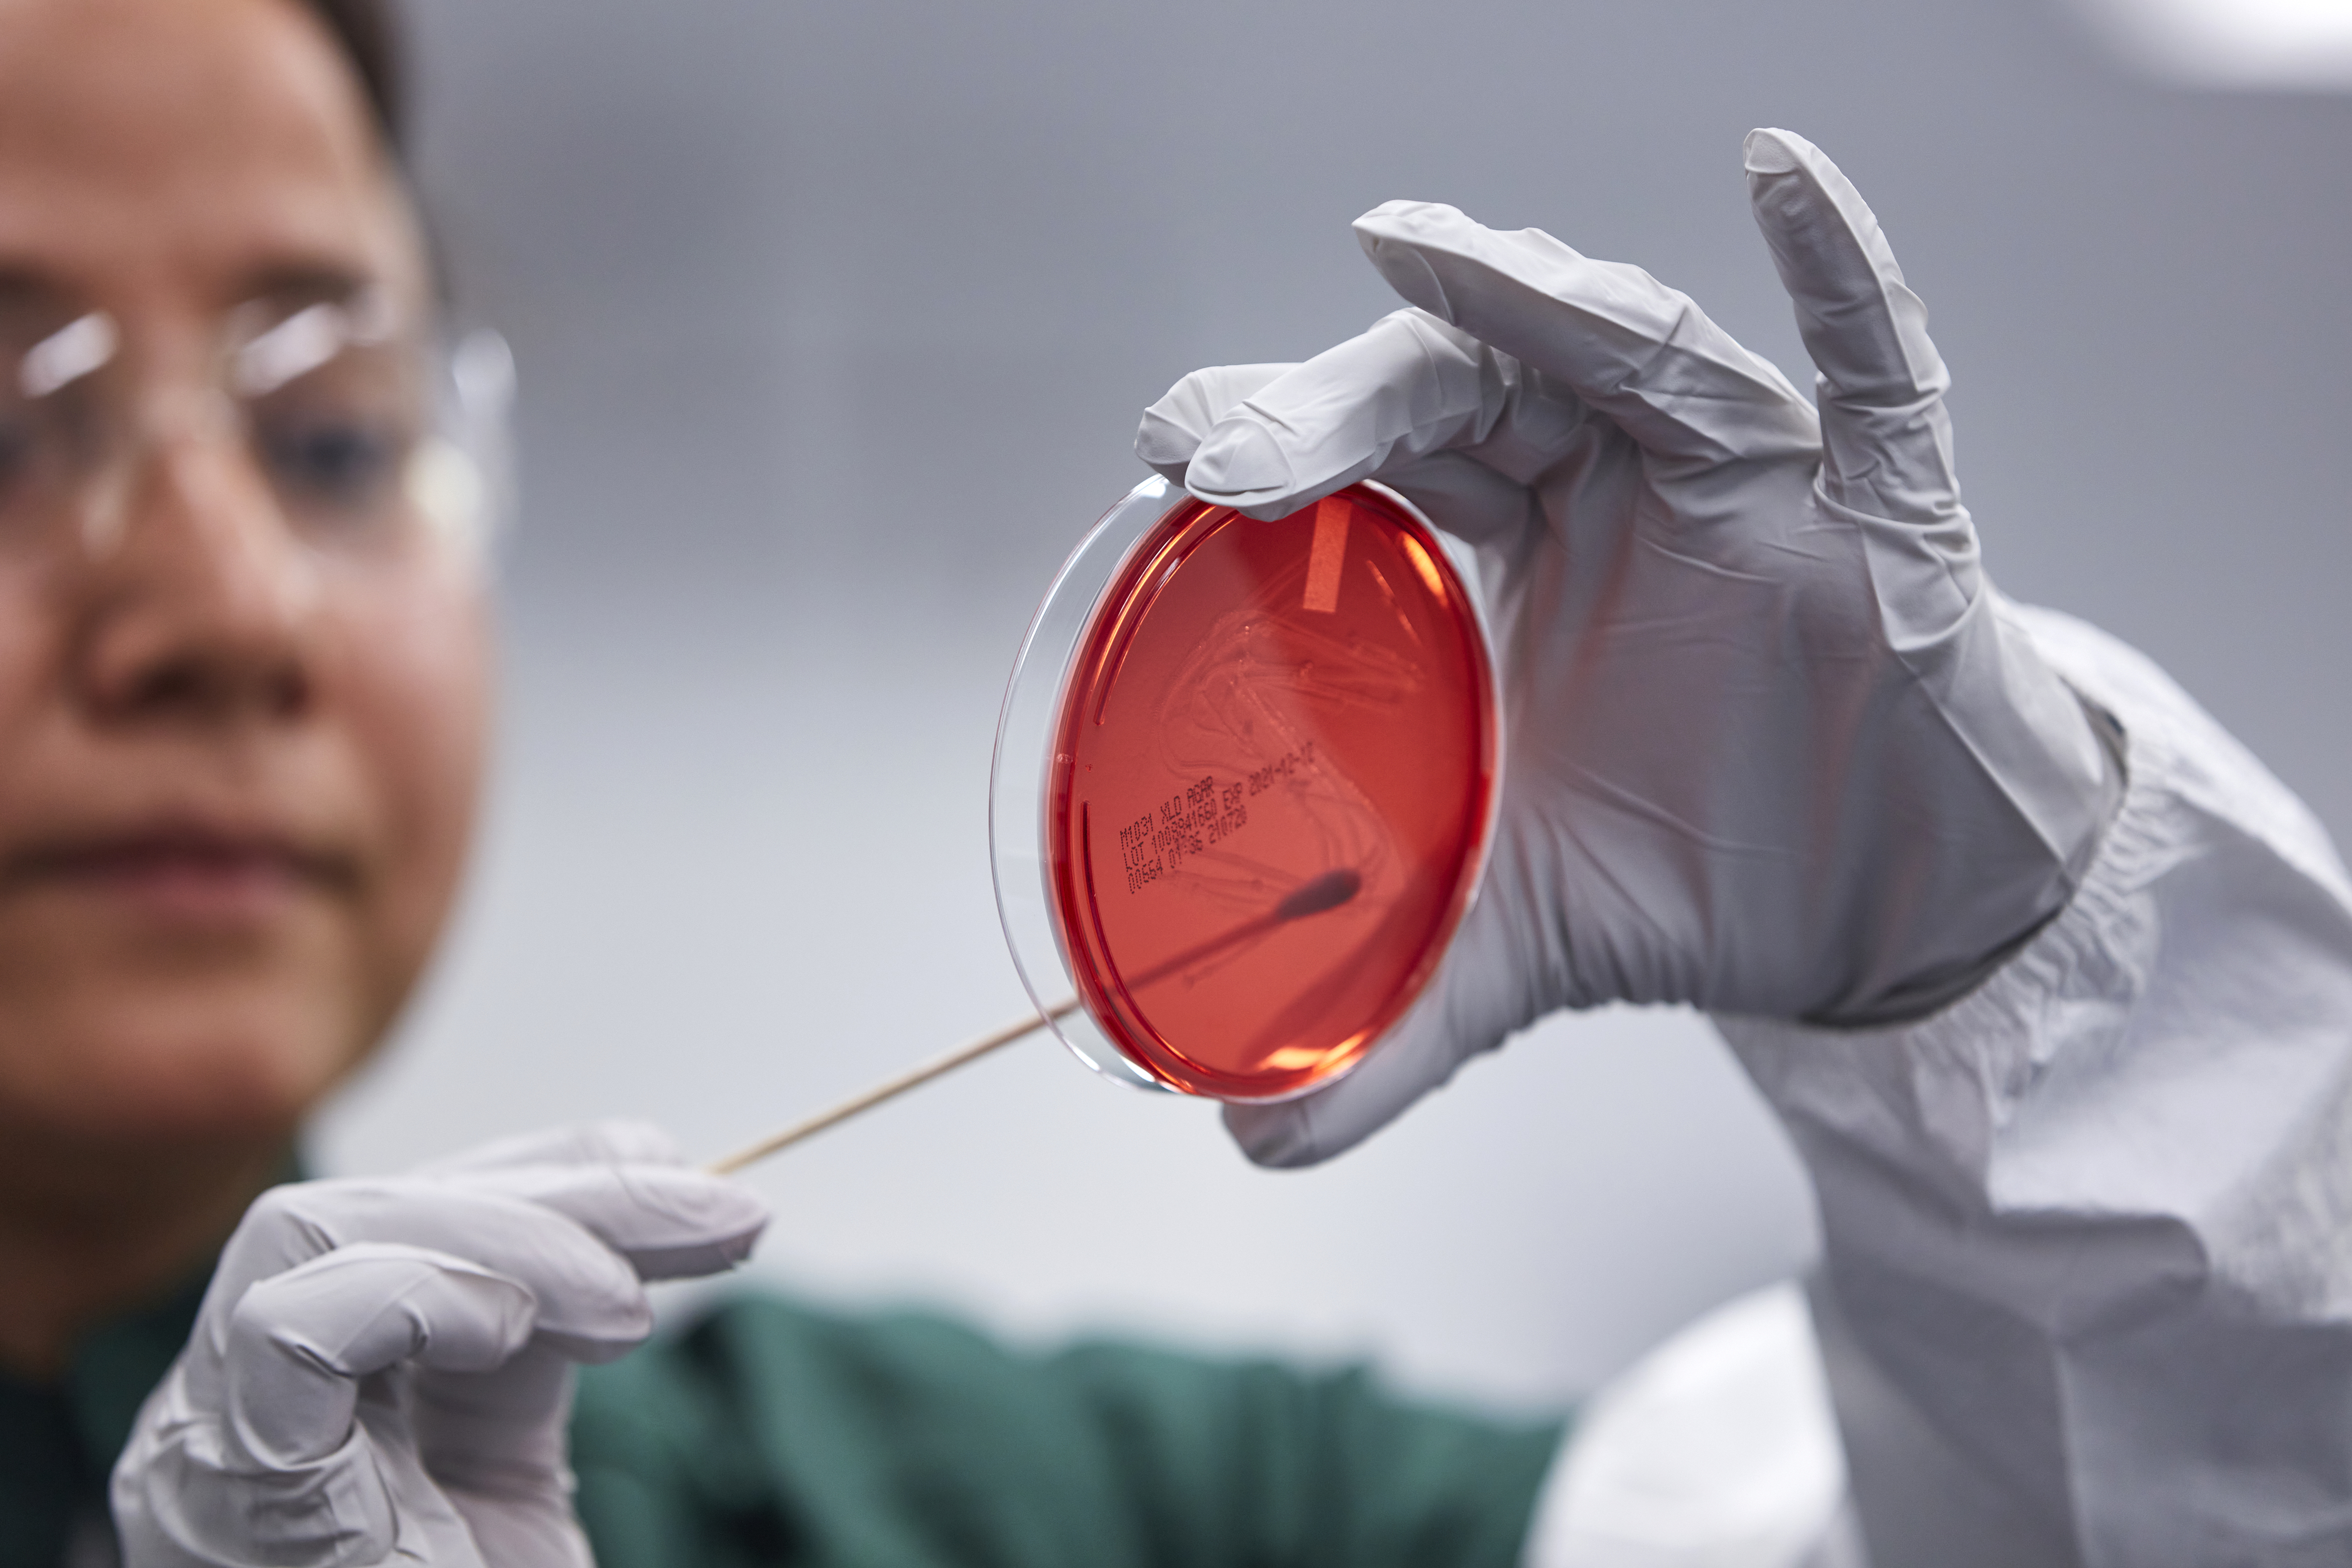

America’s partner for high-quality medicines.
All across the United States, people lean on us to deliver hundreds of high-quality, essential medicines that put better health within reach every day. We develop, manufacture, and distribute a broad range of injectable, oral, nasal, and inhalable generic and branded pharmaceutical products, including essential medicines that hospitals, physicians, and pharmacists need to treat their patients. Our well-established domestic capabilities continue to grow, and we are committed to ensuring a reliable supply of essential medications for all Americans.
















America Leans on Hikma
Quality Medicines Manufactured in the USA
"Hikma and our 2,300 dedicated US people are committed to providing Americans with a steady and reliable supply of domestically produced quality medicines.” - Dr. Hafrun Fridriksdottir, President, Hikma Rx.
US hospitals and Hikma
How our partners have leaned on us.
Hikma continues to play a major role in helping US hospitals and healthcare systems alleviate shortages of essential medicines.
Contract manufacturing offerings
How our partners have leaned on us.
A detailed look at how Hikma has brought its global manufacturing prowess to Columbus, Ohio, US and to its sterile injectable sites in Europe and in the US.
Seasonal allergy relief is here
Solving shortages
Our injectable medicines
As one of the largest manufacturers by volume of sterile injectable medicines in the US, we serve the growing needs of thousands of hospitals and millions of patients, including through our Hikma 503B compounded sterile injectable products for hospitals.
Discover moreOral, respiratory and other generic
We supply oral, respiratory and other generic and specialty products to the North American retail market, leveraging our state-of-the-art manufacturing facility in Columbus, Ohio.
Our specialty products
Our highly experienced pharmaceutical team develops, creates, manufactures and markets branded generics and in-licensed products across the US, and our portfolio continues to diversify.
Visit Hikma SpecialityOur CMO capabilities for oral, respiratory and other generic
Discover our world-class 360° pharmaceutical contract manufacturing (CMO) capabilities across a broad range of oral, respiratory and other generic dosage forms, best-in-class production facilities, and excellent quality track record.
Hikma 503B
We provide compounded sterile injectables for the US. We have a proven track record of cGMP in sterile drug manufacturing. We have extensive access to raw materials and established relationships with our hospital customers and we are FDA approved.
Discover more about 503B

Useful links
Last reviewed: July 1, 2025
Hikma has determined that the annual aggregate limit on covered promotional expenditures is set at $1,500.00 per covered Medical or Healthcare Professional.
This annual aggregate limit is based on an estimate of the maximum value of hospitality, promotional materials, and other items of value as defined herein that a Medical or Healthcare Professional may receive in a year.



